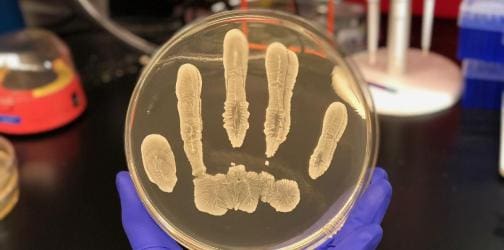

24/24
- À Barcelone, Fouad Yazourh plaide pour une lecture apaisée des mouvements de jeunesse et évoque des pourparlers exploratoires entre le Maroc et l’Algérie
- Industrie pharmaceutique : le Maroc exporte son premier médicament à base de cannabis vers l’Afrique du Sud
- Projet de loi de finances 2026 : le Maroc introduit de nouvelles mesures fiscales pour structurer l’économie et soutenir la compétitivité
- Royal Air Maroc ouvre une liaison directe Casablanca–Saint-Pétersbourg à partir de janvier 2026
- Casablanca : la police interpelle douze individus pour violences urbaines et dégradations de biens
- Sahara : Varsovie érige le plan d’autonomie en fondement crédible d’un règlement durable
- Le Maroc table sur un déficit budgétaire de 3 % du PIB en 2026, contre 3,5 % en 2025
- Le roi Mohammed VI recevra la sélection marocaine U20, championne du monde au Chili
samedi, octobre 25, 2025